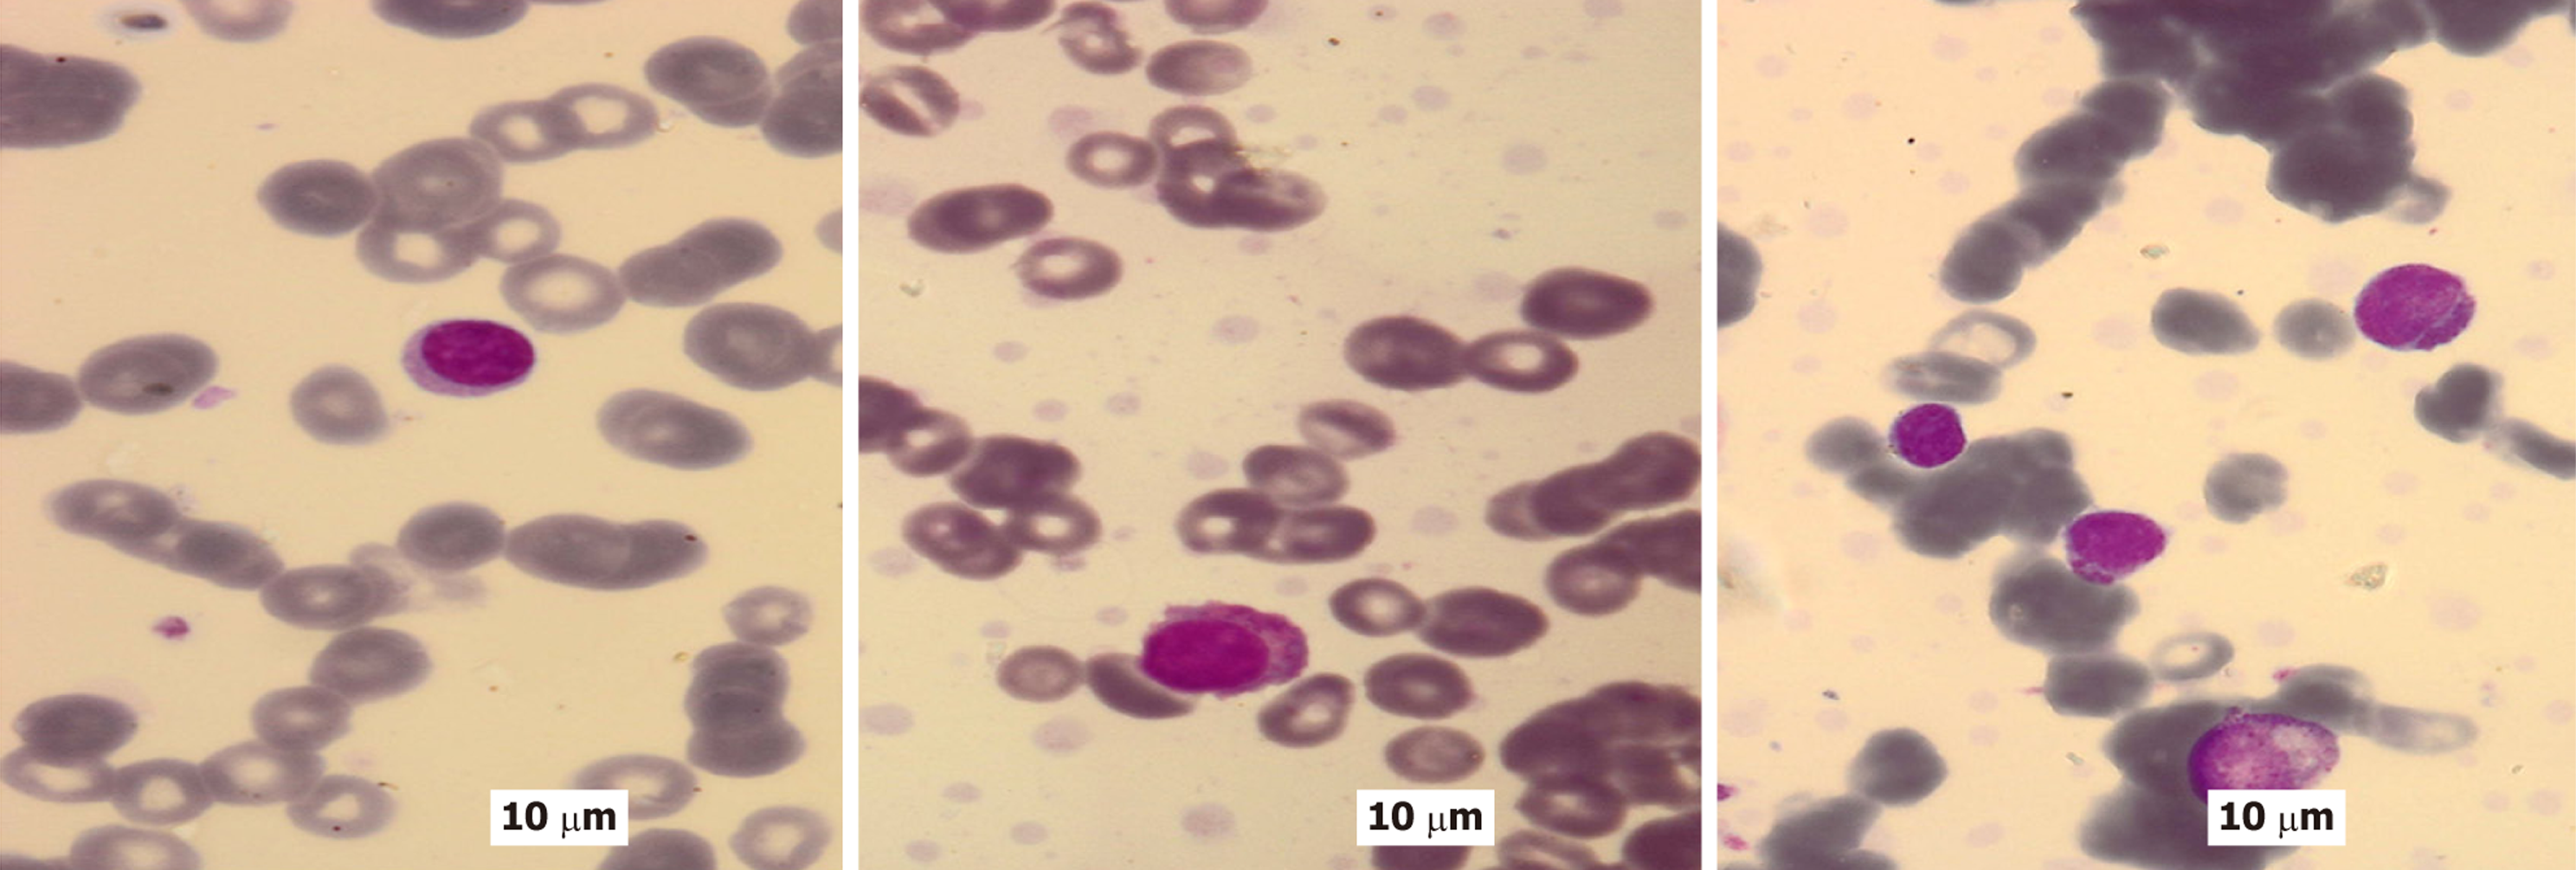

©The Author(s) 2026.
World J Clin Oncol. Jan 24, 2026; 17(1): 111426
Published online Jan 24, 2026. doi: 10.5306/wjco.v17.i1.111426
Published online Jan 24, 2026. doi: 10.5306/wjco.v17.i1.111426
Figure 1 Hematoxylin and eosin.
A-C: Hematoxylin and eosin-stained tissue sections illustrating extramedullary involvement by malignant plasma cells, characteristic of multiple myeloma, shown at progressively increasing magnifications. At low magnification (× 100), the tissue reveals widespread infiltration by densely clustered abnormal plasma cells arranged in continuous sheets, effectively displacing the normal tissue architecture (A). At intermediate magnification (× 200), the neoplastic plasma cells display significant nuclear pleomorphism, frequent binucleation, and scattered mitotic activity, with occasional foci of necrosis observed within the densely cellular environment (B). At high magnification (× 400), individual malignant plasma cells are clearly visualized, showing eccentrically positioned nuclei with a vesicular appearance, prominent nucleoli, distinct perinuclear clearing (Hof), and eosinophilic cytoplasm. Marked nuclear atypia and frequent mitotic figures are evident at this level (C); D: Hematoxylin and eosin-stained bone marrow biopsy sections demonstrate infiltration by myeloma cells in a patient with multiple myeloma with plasma cell leukemia. The marrow notably shows malignant plasma cells that display characteristic morphological features, including eccentrically located nuclei, moderately to abundantly basophilic cytoplasm, and a distinct perinuclear clearing (Hof). Occasional binucleated forms and mitotic figures are observed. Original magnification × 400.
Figure 2 Peripheral blood smears from a patient diagnosed with multiple myeloma with plasma cell leukemia exhibit distinct morph
Figure 3 Immunohistochemical staining.
A and B: Immunohistochemical staining for CD56 (neural cell adhesion molecule) using 3,3’-diaminobenzidine (DAB) chromogen highlights the expression of this marker in neoplastic plasma cells associated with multiple myeloma, both in extramedullary tissue and bone marrow samples. In the extramedullary tissue section, there is diffuse and intense CD56 staining observed on the membranes and within the cytoplasm of atypical plasma cells arranged in cohesive sheets (DAB chromogen; original magnification × 400) (A). The bone marrow biopsy shows scattered clusters and interstitial infiltrates of malignant plasma cells with strong membranous CD56 expression (DAB chromogen; original magnification × 200). Residual normal hematopoietic cells and adipocytes are also visible in the background (B); C and D: Immunohistochemical analysis of CD117 (c-Kit) expression in a bone marrow biopsy from a patient diagnosed with multiple myeloma, visualized using DAB chromogen and hematoxylin counterstain. At low magnification (× 200), scattered CD117-positive plasma cells are observed within the bone marrow, distributed among adipocytes and other marrow components (C). High magnification (× 400) reveals clusters of malignant plasma cells exhibiting strong membranous and cytoplasmic CD117 immunoreactivity, highlighting the abnormal expression pattern of c-Kit in neoplastic cells (D); E and F: Immunohistochemical staining of a bone marrow biopsy from a patient with multiple myeloma, illustrating light chain restriction using DAB chromogen with hematoxylin counterstaining. Staining for kappa light chains demonstrates strong, diffuse cytoplasmic positivity in a large population of plasma cells, indicating a predominance of kappa-restricted neoplastic cells (original magnification × 100) (E). In contrast, lambda light chain staining shows little to no expression, confirming light chain restriction to kappa (original magnification × 200) (F); G and H: Immunohistochemical analysis of a tissue section from a patient with multiple myeloma, demonstrating differential expression of cellular markers using DAB chromogen and hematoxylin counterstain. Staining for epithelial membrane antigen reveals scattered immunoreactive cells, suggestive of plasmacytoid differentiation or the presence of an epithelial component (original magnification × 200) (G). Leukocyte common antigen (CD45) staining shows focal membranous positivity in isolated lymphoid cells, consistent with hematopoietic lineage (original magnification × 400) (H); I and J: Immunohistochemical analysis of bone marrow biopsy sections from a patient diagnosed with multiple myeloma, stained for CD138. Panels (I) and (J) depict separate microscopic fields demonstrating strong membranous and cytoplasmic CD138 immunoreactivity (brown coloration, DAB chromogen), clearly delineating aggregates and sheets of neoplastic plasma cells dispersed among adipocyte-rich marrow. These findings are indicative of marrow involvement by plasma cell neoplasia. Original magnification: I (× 200), J (× 400).
Figure 4 Immunohistochemical evaluation of murine double minute 2 nuclear expression in bone marrow samples of patients with mul
Figure 5 Kaplan-Meier curves depicting relapse-free survival in months according to murine double minute 2 status in patients with plasma cell neoplasms.
MDM2: Murine double minute 2.
- Citation: Ebrahim NAA, Elfandy H, Arafat AMA, Darwish AD, Eltohamy MI. Evaluating murine double minute 2 status as a stratification tool for risk-adapted management in plasma cell neoplasms. World J Clin Oncol 2026; 17(1): 111426
- URL: https://www.wjgnet.com/2218-4333/full/v17/i1/111426.htm
- DOI: https://dx.doi.org/10.5306/wjco.v17.i1.111426